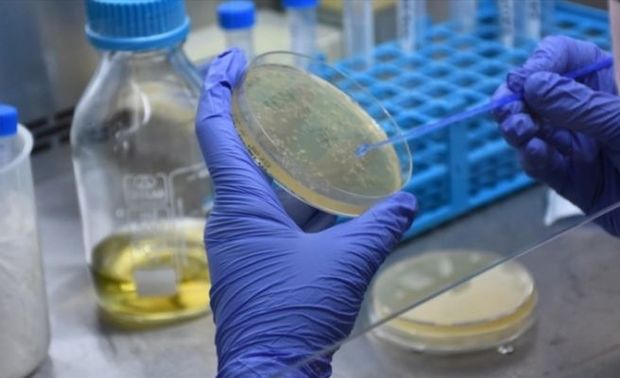
Число инфицированных коронавирусом в мире превысило 95 млн

По данным на утро 18 января, число инфицированных коронавирусом (COVID-19) в мире достигло 95 484 666.
За весь период пандемии скончались 2 039 695 человек, выздоровели - 68 170 260.
Больше всего инфицированных в США - 24 482 050. На 2-м месте - Индия (10 572 672), 3-м - Бразилия (8 488 099). В первую пятерку также входят Россия (3 568 209) и Великобритания (3 395 959).
По числу жертв инфекции и выздоровевших лидируют Соединенные Штаты - 407 202 и 14 428 351 соответственно.
Турция (2 387 101 заболевший) занимает 7-е место, Иран (1 330 411) - 16-е.
В Армении COVID-19 заболели 164 586 человек, в Грузии - 247 805.
Среди соседних стран наиболее высокая смертность от COVID-19 зафиксирована в Иране - 56 803 летальных исхода.
На сегодня в Азербайджане подтверждены 227 273 случая инфицирования коронавирусом, 215 268 человек вылечились, 3 009 - скончались.
7News.Az